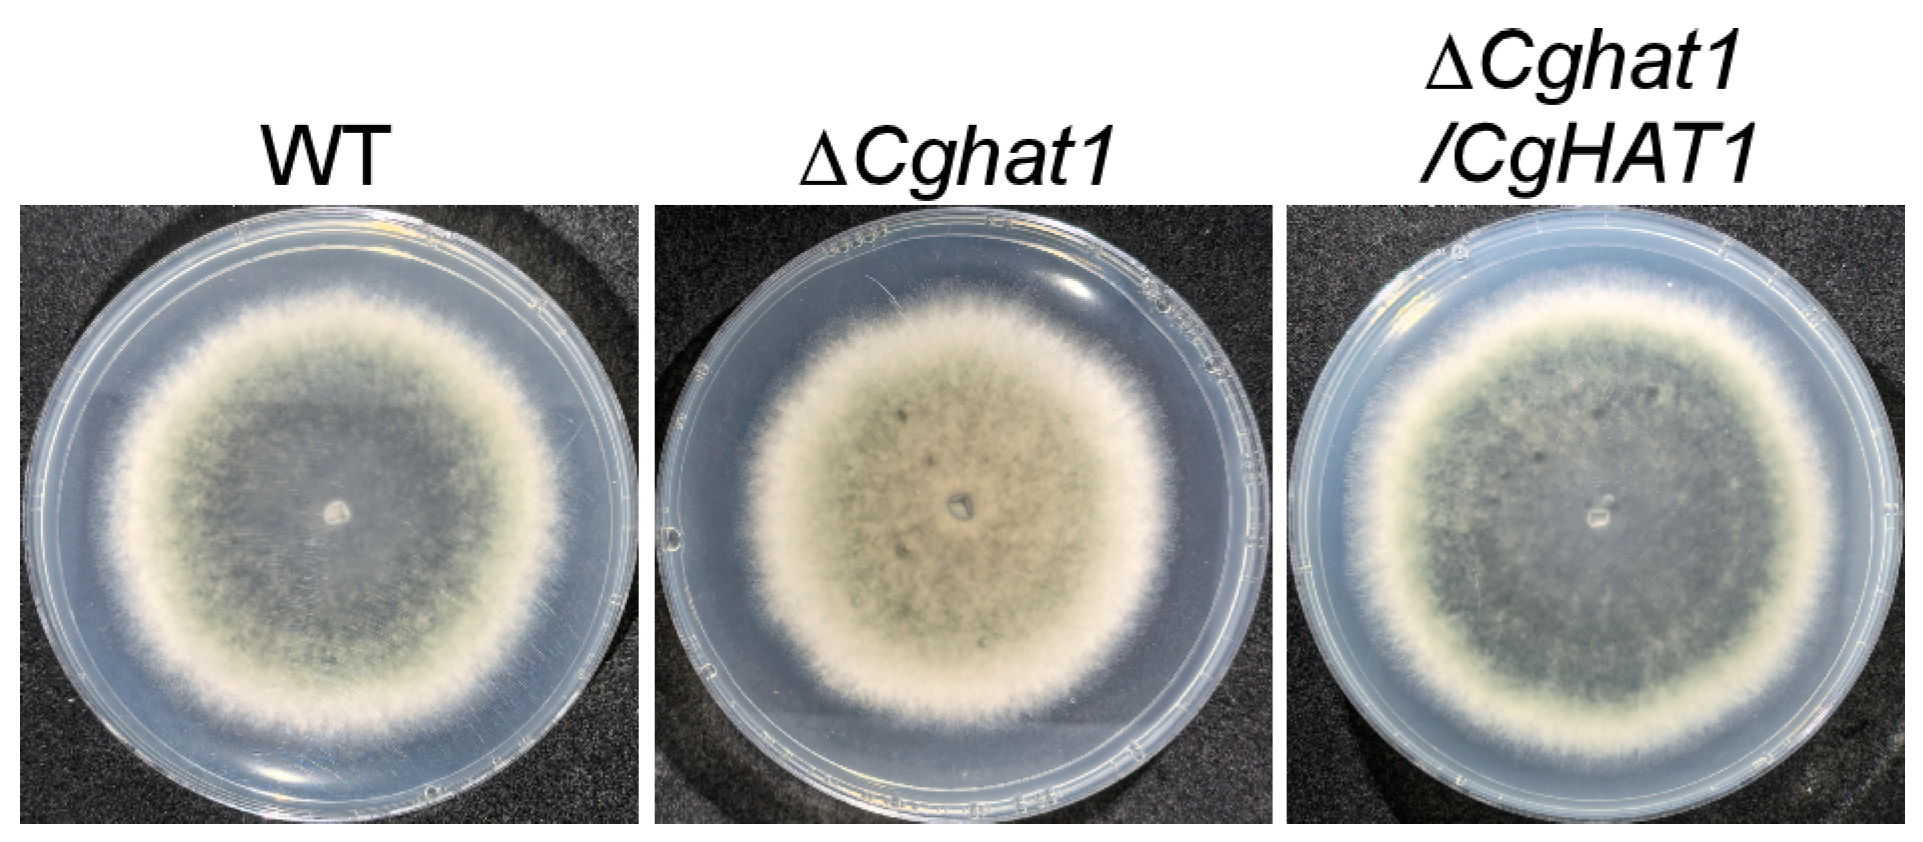

The Histone Acetyltransferase CgHat1 Regulates Growth, Development, and Pathogenicity of Colletotrichum gloeosporioides
Abstract
1. Introduction
2. Materials and Methods
2.1. Strains and Culture Conditions
2.2. Targeted Gene Deletion, Complementation and Subcellular Localization
2.3. Growth and Stress Response Assays
2.4. Conidiation, Appressorial Formation and Pathogenicity Assays
2.5. Protein Extraction and Acetylation Analysis
2.6. Bioinformatics and Statistical Analysis
3. Results
3.1. Identification and Bioinformatic Analysis of CgHat1
3.2. CgHat1 Is Localized to the Nucleus
3.3. CgHat1 Regulates the Acetylation of H4K5 and H4K12
3.4. CgHat1 Is Important for the Growth on PDA Media and for the Colony Pigmentation
3.5. CgHat1 Is Critical for Asexual Development
3.6. CgHat1 Is Required for Full Virulence
3.7. CgHat1 Plays Important Roles in Conidial Germination and Appressorial Formation
3.8. CgHat1 Regulates the Response to ER Stress
4. Discussion
5. Conclusions
Supplementary Materials
Author Contributions
Funding
Institutional Review Board Statement
Informed Consent Statement
Data Availability Statement
Conflicts of Interest
Abbreviations
| CM | Complete medium |
| CR | Congo red |
| DTT | Dimethyl sulfoxide |
| ER | Endoplasmic reticulum |
| HAT | Histone acetyltransferase |
| MM | Minimal medium |
| PCR | Polymerase Chain Reaction |
| PDA | Potato Dextrose Agar |
References
- Dean, R.; Van Kan, J.A.; Pretorius, Z.A.; Hammond-Kosack, K.E.; Di Pietro, A.; Spanu, P.D.; Rudd, J.J.; Dickman, M.; Kahmann, R.; Ellis, J.; et al. The Top 10 fungal pathogens in molecular plant pathology. Mol. Plant Pathol. 2012, 13, 414–430. [Google Scholar] [CrossRef]
- O’Connell, R.J.; Thon, M.R.; Hacquard, S.; Amyotte, S.G.; Kleemann, J.; Torres, M.F.; Damm, U.; Buiate, E.A.; Epstein, L.; Alkan, N.; et al. Lifestyle transitions in plant pathogenic Colletotrichum fungi deciphered by genome and transcriptome analyses. Nat. Genet. 2012, 44, 1060–1065. [Google Scholar] [CrossRef]
- Weir, B.S.; Johnston, P.R.; Damm, U. The Colletotrichum gloeosporioides species complex. Stud. Mycol. 2012, 73, 115–180. [Google Scholar] [CrossRef]
- Zhang, Y.; An, B.; Wang, W.; Zhang, B.; He, C.; Luo, H.; Wang, Q. Actin-bundling protein fimbrin regulates pathogenicity via organizing F-actin dynamics during appressorium development in Colletotrichum gloeosporioides. Mol. Plant Pathol. 2022, 23, 1472–1486. [Google Scholar] [CrossRef]
- Yang, J.; Li, B.; Pan, Y.T.; Wang, P.; Sun, M.L.; Kim, K.T.; Sun, H.; Ye, J.R.; Jiao, Z.; Lee, Y.H.; et al. Phospho-code of a conserved transcriptional factor underpins fungal virulence. BMC Biol. 2024, 22, 179. [Google Scholar] [CrossRef]
- Liu, S.; Bu, Z.; Zhang, X.; Chen, Y.; Sun, Q.; Wu, F.; Guo, S.; Zhu, Y.; Tan, X. The new CFEM protein CgCsa required for Fe(3+) homeostasis regulates the growth, development, and pathogenicity of Colletotrichum gloeosporioides. Int. J. Biol. Macromol. 2024, 274, 133216. [Google Scholar] [CrossRef]
- Bannister, A.J.; Kouzarides, T. Regulation of chromatin by histone modifications. Cell Res. 2011, 21, 381–395. [Google Scholar] [CrossRef] [PubMed]
- Kurdistani, S.K.; Grunstein, M. Histone acetylation and deacetylation in yeast. Nat. Rev. Mol. Cell Biol. 2003, 4, 276–284. [Google Scholar] [CrossRef]
- Suter, B.; Pogoutse, O.; Guo, X.; Krogan, N.; Lewis, P.; Greenblatt, J.F.; Rine, J.; Emili, A. Association with the origin recognition complex suggests a novel role for histone acetyltransferase Hat1p/Hat2p. BMC Biol. 2007, 5, 38. [Google Scholar] [CrossRef] [PubMed]
- Wu, H.; Moshkina, N.; Min, J.; Zeng, H.; Joshua, J.; Zhou, M.M.; Plotnikov, A.N. Structural basis for substrate specificity and catalysis of human histone acetyltransferase 1. Proc. Natl. Acad. Sci. USA 2012, 109, 8925–8930. [Google Scholar] [CrossRef] [PubMed]
- Qin, S.; Parthun, M.R. Histone H3 and the histone acetyltransferase Hat1p contribute to DNA double-strand break repair. Mol. Cell Biol. 2002, 22, 8353–8365. [Google Scholar] [CrossRef]
- Tscherner, M.; Stappler, E.; Hnisz, D.; Kuchler, K. The histone acetyltransferase Hat1 facilitates DNA damage repair and morphogenesis in Candida albicans. Mol. Microbiol. 2012, 86, 1197–1214. [Google Scholar] [CrossRef]
- Yin, Z.; Chen, C.; Yang, J.; Feng, W.; Liu, X.; Zuo, R.; Wang, J.; Yang, L.; Zhong, K.; Gao, C.; et al. Histone acetyltransferase MoHat1 acetylates autophagy-related proteins MoAtg3 and MoAtg9 to orchestrate functional appressorium formation and pathogenicity in Magnaporthe oryzae. Autophagy 2019, 15, 1234–1257. [Google Scholar] [CrossRef]
- Bruno, K.S.; Tenjo, F.; Li, L.; Hamer, J.E.; Xu, J.R. Cellular localization and role of kinase activity of PMK1 in Magnaporthe grisea. Eukaryot. Cell 2004, 3, 1525–1532. [Google Scholar] [CrossRef]
- Schneider, C.A.; Rasband, W.S.; Eliceiri, K.W. NIH Image to ImageJ: 25 years of image analysis. Nat. Methods 2012, 9, 671–675. [Google Scholar] [CrossRef] [PubMed]
- Fukada, F.; Kodama, S.; Nishiuchi, T.; Kajikawa, N.; Kubo, Y. Plant pathogenic fungi Colletotrichum and Magnaporthe share a common G(1) phase monitoring strategy for proper appressorium development. New Phytol. 2019, 222, 1909–1923. [Google Scholar] [CrossRef] [PubMed]
- Fukada, F.; Kubo, Y. Colletotrichum orbiculare Regulates Cell Cycle G1/S Progression via a Two-Component GAP and a GTPase to Establish Plant Infection. Plant Cell 2015, 27, 2530–2544. [Google Scholar] [CrossRef]
- Yin, Z.; Zhang, X.; Wang, J.; Yang, L.; Feng, W.; Chen, C.; Gao, C.; Zhang, H.; Zheng, X.; Wang, P.; et al. MoMip11, a MoRgs7-interacting protein, functions as a scaffolding protein to regulate cAMP signaling and pathogenicity in the rice blast fungus Magnaporthe oryzae. Environ. Microbiol. 2018, 20, 3168–3185. [Google Scholar] [CrossRef]
- Cheng, Y.T.; Zhang, L.; He, S.Y. Plant-microbe interactions facing environmental challenge. Cell Host Microbe 2019, 26, 183–192. [Google Scholar] [CrossRef] [PubMed]
- Guo, R.; Chen, J.; Mitchell, D.L.; Johnson, D.G. GCN5 and E2F1 stimulate nucleotide excision repair by promoting H3K9 acetylation at sites of damage. Nucleic Acids Res. 2011, 39, 1390–1397. [Google Scholar] [CrossRef]
- Strenkert, D.; Schmollinger, S.; Sommer, F.; Schulz-Raffelt, M.; Schroda, M. Transcription factor-dependent chromatin remodeling at heat shock and copper-responsive promoters in Chlamydomonas reinhardtii. Plant Cell 2011, 23, 2285–2301. [Google Scholar] [CrossRef] [PubMed]
- Jeon, J.; Kwon, S.; Lee, Y.H. Histone acetylation in fungal pathogens of plants. Plant Pathol. J. 2014, 30, 1–9. [Google Scholar] [CrossRef]
- Zhang, S.; Liang, M.; Naqvi, N.I.; Lin, C.; Qian, W.; Zhang, L.H.; Deng, Y.Z. Phototrophy and starvation-based induction of autophagy upon removal of Gcn5-catalyzed acetylation of Atg7 in Magnaporthe oryzae. Autophagy 2017, 13, 1318–1330. [Google Scholar] [CrossRef]
- Qian, H.; Song, L.; Wang, L.; Yang, Q.; Wu, R.; Du, J.; Zheng, B.; Liang, W. FolIws1-driven nuclear translocation of deacetylated FolTFIIS ensures conidiation of Fusarium oxysporum. Cell Rep. 2024, 43, 114588. [Google Scholar] [CrossRef] [PubMed]
- Zhang, Q.; Chen, L.; Yu, X.; Liu, H.; Akhberdi, O.; Pan, J.; Zhu, X. A B-type histone acetyltransferase Hat1 regulates secondary metabolism, conidiation, and cell wall integrity in the taxol-producing fungus Pestalotiopsis microspora. J. Basic Microbiol. 2016, 56, 1380–1391. [Google Scholar] [CrossRef]
- Tang, W.; Jiang, H.; Aron, O.; Wang, M.; Wang, X.; Chen, J.; Lin, B.; Chen, X.; Zheng, Q.; Gao, X.; et al. Endoplasmic reticulum-associated degradation mediated by MoHrd1 and MoDer1 is pivotal for appressorium development and pathogenicity of Magnaporthe oryzae. Environ. Microbiol. 2020, 22, 4953–4973. [Google Scholar] [CrossRef]
- Yin, Z.; Feng, W.; Chen, C.; Xu, J.; Li, Y.; Yang, L.; Wang, J.; Liu, X.; Wang, W.; Gao, C.; et al. Shedding light on autophagy coordinating with cell wall integrity signaling to govern pathogenicity of Magnaporthe oryzae. Autophagy 2020, 16, 900–916. [Google Scholar] [CrossRef]
- Kawamura, C.; Moriwaki, J.; Kimura, N.; Fujita, Y.; Fuji, S.; Hirano, T.; Koizumi, S.; Tsuge, T. The melanin biosynthesis genes of Alternaria alternata can restore pathogenicity of the melanin-deficient mutants of Magnaporthe grisea. Mol. Plant Microbe Interact. 1997, 10, 446–453. [Google Scholar] [CrossRef]
- Talbot, N.J. On the trail of a cereal killer: Exploring the biology of Magnaporthe grisea. Annu. Rev. Microbiol. 2003, 57, 177–202. [Google Scholar] [CrossRef]
- Qi, Z.; Liu, M.; Dong, Y.; Zhu, Q.; Li, L.; Li, B.; Yang, J.; Li, Y.; Ru, Y.; Zhang, H.; et al. The syntaxin protein (MoSyn8) mediates intracellular trafficking to regulate conidiogenesis and pathogenicity of rice blast fungus. New Phytol. 2016, 209, 1655–1667. [Google Scholar] [CrossRef] [PubMed]

Disclaimer/Publisher’s Note: The statements, opinions and data contained in all publications are solely those of the individual author(s) and contributor(s) and not of MDPI and/or the editor(s). MDPI and/or the editor(s) disclaim responsibility for any injury to people or property resulting from any ideas, methods, instructions or products referred to in the content. |
© 2025 by the authors. Licensee MDPI, Basel, Switzerland. This article is an open access article distributed under the terms and conditions of the Creative Commons Attribution (CC BY) license (https://creativecommons.org/licenses/by/4.0/).
Share and Cite
Jia, B.; Zhou, Q.; Liu, Y.; Chen, Z.; Liao, M.; Zhu, C.; Xiao, C.; Ai, J. The Histone Acetyltransferase CgHat1 Regulates Growth, Development, and Pathogenicity of Colletotrichum gloeosporioides. J. Fungi 2025, 11, 768. https://doi.org/10.3390/jof11110768
Jia B, Zhou Q, Liu Y, Chen Z, Liao M, Zhu C, Xiao C, Ai J. The Histone Acetyltransferase CgHat1 Regulates Growth, Development, and Pathogenicity of Colletotrichum gloeosporioides. Journal of Fungi. 2025; 11(11):768. https://doi.org/10.3390/jof11110768
Chicago/Turabian StyleJia, Binghong, Qian Zhou, Yiping Liu, Zhuohua Chen, Moxiang Liao, Chunsheng Zhu, Caisheng Xiao, and Junwen Ai. 2025. "The Histone Acetyltransferase CgHat1 Regulates Growth, Development, and Pathogenicity of Colletotrichum gloeosporioides" Journal of Fungi 11, no. 11: 768. https://doi.org/10.3390/jof11110768
APA StyleJia, B., Zhou, Q., Liu, Y., Chen, Z., Liao, M., Zhu, C., Xiao, C., & Ai, J. (2025). The Histone Acetyltransferase CgHat1 Regulates Growth, Development, and Pathogenicity of Colletotrichum gloeosporioides. Journal of Fungi, 11(11), 768. https://doi.org/10.3390/jof11110768
